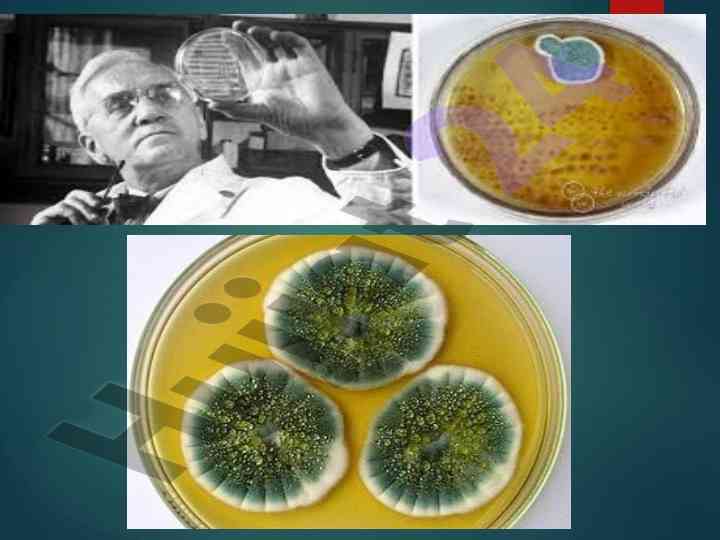

Antibiotiklar mikroorganizmga qarshi ta'siri

We
Muallif:
Web dizayner
Hujjat ma'lumotlari
Kategoriya:
Taqdimotlar (slaydlar) Format:
pptx Sahifalar:
19 bet Ko'rilgan:
1 marta Sotilgan:
0 marta Hajmi:
0.84 MB Narxi:
3,000 so'mMahsulot tavsifi:
Antibiotiklar mikroorganizmlar, hayvonlar va o'simliklardan olingan kuchli ta'sir etuvchi moddalardir. Ular turlarga bo'linib, klinik qo'llanilishiga ko'ra tasniflanadi.










